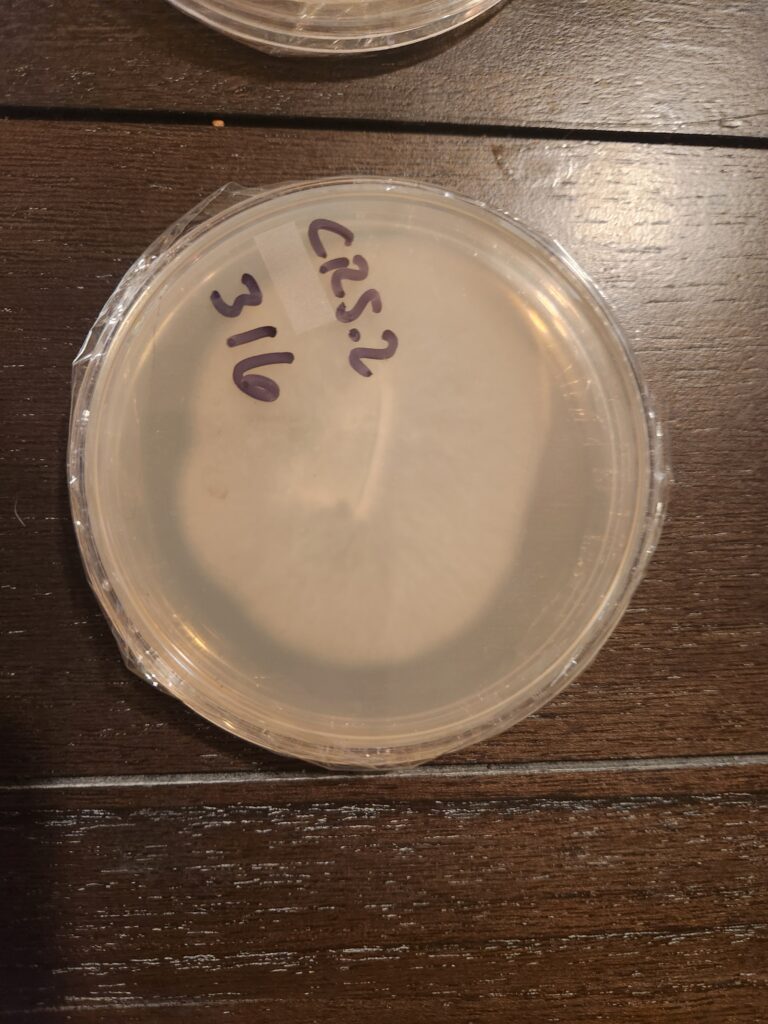
Agar by Mycology Men

So, you’re looking to grow some mushrooms? Well, you’ve come to the right place to start your intellectual journey! We are going to discuss liquid culture vs agar for growing mushrooms. The first thing you need to know about growing mushrooms is that you MUST have clean & healthy cultures to inoculate grains (read more about the full growth process in our article How to Use Liquid Cultures).
Typically, beginners usually come across liquid cultures and agar as the starting point for their grow. The issue is that these are commonly misunderstood. You may not even know the difference between the two.
In this article, we are going to detail exactly what are liquid cultures and agar, which is better for your goals, and how to use them together. We hope this can set you on the right path so you can have a successful mushroom growing experience. Now, let's learn about liquid culture vs agar!
A liquid culture is a syringe filled with what you need to grow your first batch of mushrooms. Inside the syringe is living mycelium suspended in a liquid broth loaded with nutrients to help the mushrooms grow. Without getting into too much detail (you can get into more detail in our article on growing with liquid cultures linked above), you inject the contents of the liquid culture into grains, let the grains colonize, then mix the colonized grains with a substrate and let that grow until the mushrooms are ready for harvest.
Liquid cultures are preferred by many growers because they colonize grains quickly, it is easy to scale up production for larger grows, and it is pretty easy to find high quality liquid cultures for sale online.
The main risk of using liquid cultures is contamination. It can be tricky to spot to the untrained eye. Even pros can get tripped up now and then. Once you use a contaminated liquid culture, it can be damn near impossible to save the grains. If you buy your liquid culture from a reputable producer, you should be fine. Another downside is that liquid cultures are genetically stable so you won’t be able to search for and grow stronger genetics than what you already have inside the syringe.

Agar (also sometimes referred to as agar plates) is a petri dish filled with a solid nutrient medium. It is kind of like fungi jello. Spores from a mushroom are spread on the agar and allowed to grow. Agar itself contains no fungi. It is simply the growing medium for fungi. If you want to learn more about making agar plates, give this article a read - How to Make Agar at Home.
Agar has the benefit of allowing users to catch any contamination early on. It will be visible on the agar plate alongside the mycelium. You can even clean your agar so you can keep the process going.

Agar is also beneficial if you want to isolate strong genetics from a particular strain. As we mentioned above, you can start with spores on agar. Each set of spores will produce slightly different mushrooms all within the same strain. Spore A might grow small and unflavorful shiitake while spore B grows the best shiitake mushrooms you’ve ever had. Agar allows you to pick and choose the genetics you really want.
There are a few downsides to using agar. For one, it takes a relatively longer time to reach harvest when compared to liquid cultures. Not only that, but it requires more supplies like a still air box or flow hood (tools to keep your agar clean and sterile while working with it).
If you want to develop a structurally sound mycology foundation, then working with agar is the way to go. It will teach you all about sterile techniques, genetics, and the growth process from spore to harvest.
If you want to grow fast then liquid cultures are for you. Assuming you have purchased your liquid culture from a reputable producer, you can get right into inoculating grains as soon as you receive your syringe. Liquid cultures are also best for those who wish to inoculate multiple bags of grains at a time. They are ideal for scaling up production.
There are a few scenarios in which starting from agar is the best choice over liquid cultures. The first scenario is if you have a desire to develop a really strong foundation in mycology. Starting from spore to make agar will teach you mycology from top to bottom.
Another reason you may choose to start with agar is if you want to hunt for strong genetics of the mushroom strain you wish to grow. Liquid cultures come as-is. There is no making the mycelium inside genetically stronger. With agar, you can select the genetics that you desire.
A third reason you might want to consider starting with agar is if you want to verify there is no contamination. As we mentioned above, it can be tricky to spot if a liquid culture is contaminated and if you use a contaminated liquid culture to inoculate grains, well there’s very little chance of coming back from that. When you use agar, you can physically see contamination spreading on the agar plate. Not only can you spot it, but you can also clean it. So if you want to verify cleanliness, use agar over liquid cultures.

Brand new to mycology: Consider starting with agar. You will learn everything you need to know and when you get to the inoculation phase, you will have a guaranteed clean starting point.
You want fast results: Start with a liquid culture. Starting from agar takes longer to reach harvest. Just do yourself a favor and check that the liquid culture producer you buy from is reputable. If it is contaminated and you use it, you just wasted time and supplies.
You want to learn everything about mycology: Start with agar and work your way through the entire process up to harvest and additional harvests (flushes).
You want to scale up: Liquid cultures are ideal for scaling your production. But you might consider starting with agar to select the genetics you want to grow in bulk. If you don’t start with agar, you're stuck growing whatever came in your liquid culture.